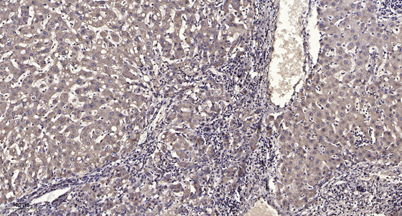

FILA rabbit pAb
 One-click to copy product information
One-click to copy product information$148.00/50µL $248.00/100µL
| 50 µL | $148.00 |
| 100 µL | $248.00 |
Overview
| Product name: | FILA rabbit pAb |
| Reactivity: | Human;Rat;Mouse; |
| Source: | Rabbit |
| Dilutions: | IHC-p 1:50-300 |
| Immunogen: | Synthesized peptide derived from part region of human protein |
| Storage: | -20°C/1 year |
| Clonality: | Polyclonal |
| Isotype: | IgG |
| Concentration: | 1 mg/ml |
| Observed Band: | 446kD |
| GeneID: | 2312 |
| Human Swiss-Prot No: | P20930 |
| Cellular localization: | Cytoplasmic granule . In the stratum granulosum of the epidermis, localized within keratohyalin granules (PubMed:1429717). In granular keratinocytes and in lower corneocytes, colocalizes with calpain-1/CAPN1 (PubMed:21531719). . |
| Background: | The protein encoded by this gene is an intermediate filament-associated protein that aggregates keratin intermediate filaments in mammalian epidermis. It is initially synthesized as a polyprotein precursor, profilaggrin (consisting of multiple filaggrin units of 324 aa each), which is localized in keratohyalin granules, and is subsequently proteolytically processed into individual functional filaggrin molecules. Mutations in this gene are associated with ichthyosis vulgaris.[provided by RefSeq, Dec 2009], |

 Manual
Manual